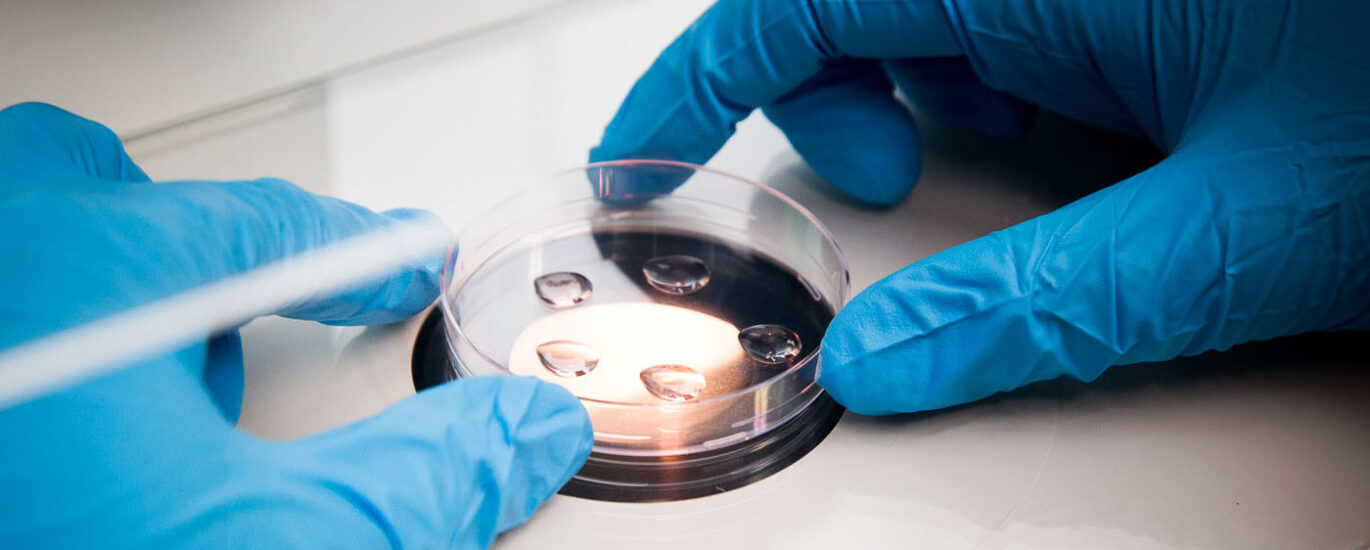
Pneumococcal Testing Market

A new market analysis reveals the global pneumococcal testing market is poised for robust expansion, with its value projected to surge from an estimated USD 2.2 billion in 2025 to USD 6.4 billion by 2035. This significant growth, representing a compound annual growth rate (CAGR) of 11.2%, is driven by increasing global awareness of pneumococcal infections and the continuous advancement of diagnostic technologies.
The market’s compelling forecast is a direct reflection of escalating efforts to combat respiratory illnesses, particularly among vulnerable populations. A detailed study shows a negative BPS growth in the H1-2025 outlook compared to the projected period, but an overall increase in BPS by 0.03 units compared to H1-2024. This change is attributed to the high prevalence of pneumococcal carriage rates, the adoption of advanced pathogen identification methods like multi-locus sequence analysis (MLSA), and a high diagnostic yield of pneumococcal testing. The introduction of pneumococcal conjugate vaccines and the development of novel biomarkers and detection methods have also been instrumental in this market’s expansion.
Click Here for More Information:- https://www.futuremarketinsights.com/reports/pneumococcal-testing-market
Growth Catalysts & Market Segmentation
The pneumococcal testing market is segmented by Method, Product, Technology, End User, and Region. Key growth drivers and market leaders are emerging across these segments:
- Immunodiagnostics Lead the Way: The Immunodiagnostics segment is set to dominate, accounting for an impressive 43.6% of the market’s revenue in 2025. Its popularity stems from its accuracy, scalability, and compatibility with automated systems, making it a staple in emergency departments and outpatient clinics.
- Consumables Power Daily Operations: In terms of product, consumables are projected to hold the largest share at 57.3% in 2025. This dominance is a result of the consistent demand for reagents, assay kits, and test cartridges, which are essential for maintaining high-throughput diagnostic operations in laboratories.
- ELISA Remains the Technological Backbone: Enzyme Linked Immunosorbent Assay (ELISA) is forecasted to maintain its leadership among technologies, capturing 38.9% of the market revenue in 2025. The technology’s high sensitivity and specificity, coupled with its ability to process multiple samples efficiently, make it a preferred choice for scalable and accurate testing.
- Hospitals as Primary Drivers: Hospitals are expected to be the leading end-users, holding a 55.3% share of the market in 2025. This is driven by the high volume of patients, adoption of advanced diagnostic equipment, and favorable reimbursement policies for a variety of diagnostic tests.
Regional Powerhouses: North America and Asia-Pacific
North America, particularly the USA, is a dominant force in the market. The USA is anticipated to account for 82.9% of the North American market in 2025. The region’s growth is fueled by the popularity of point-of-care (POC) tests, a growing geriatric population, and a strong push for advanced PCR-based technologies. Similarly, Germany is a lucrative market in Europe, driven by government initiatives to improve healthcare infrastructure and a high incidence of the disease. In the Asia-Pacific region, India is expected to experience the highest CAGR at 13.7% over the forecast period, fueled by a rising elderly population and increasing awareness of pneumococcal testing.
Competitive Landscape and Market Positioning
The competitive landscape is marked by a number of key players who are strategically positioning themselves for market share. Companies like Thermo Fisher Scientific Inc., Abbott Laboratories, F-Hoffmann la Roche Ltd., Hologic Inc., bioMerieux, and others are at the forefront. Their strategies include strategic alliances, product launches, and acquisitions to capitalize on market opportunities. Recent examples include Quest Diagnostics’ collaboration with Walmart to offer consumer-initiated laboratory testing, and Quidel Corporation’s acquisition of Ortho, a move to expand its in-vitro diagnostics portfolio.
These players are focusing on a multi-pronged approach, leveraging their expertise in various segments. Some, like Abbott Laboratories and Thermo Fisher Scientific, are known for their broad portfolios of diagnostic solutions, offering everything from consumables to analyzers. Others, such as Quidel and Quest Diagnostics, are expanding access to testing through strategic partnerships and consumer-facing initiatives. The market is also seeing players innovate with new technologies, such as advanced PCR-based technologies and multiplex assays, to improve the speed and accuracy of pneumococcal detection.
Challenges and Outlook
While the market’s future is bright, challenges such as the high cost of testing and limited reimbursement for new and expensive diagnostic tests remain. However, the market’s momentum is expected to be sustained by a growing demand for rapid and accurate diagnostics, particularly in the face of rising antibiotic resistance and the continued push for effective immunization strategies.
The market outlook for 2025 to 2035 is exceptionally positive, with continued innovation in detection methods and a strong focus on scalable diagnostic solutions expected to fuel a USD 4.2 billion increase in market value. The persistent need for early detection of pneumococcal infections, coupled with advancements in diagnostic technologies and a growing global awareness of the disease, positions the pneumococcal testing market for a period of sustained and significant growth.
Get Sample Report: – https://www.futuremarketinsights.com/reports/sample/rep-gb-11289
About Future Market Insights (FMI)
Future Market Insights, Inc. (ESOMAR certified, recipient of the Stevie Award, and a member of the Greater New York Chamber of Commerce) offers profound insights into the driving factors that are boosting demand in the market. FMI stands as the leading global provider of market intelligence, advisory services, consulting, and events for the Packaging, Food and Beverage, Consumer Technology, Healthcare, Industrial, and Chemicals markets. With a vast team of over 400 analysts worldwide, FMI provides global, regional, and local expertise on diverse domains and industry trends across more than 110 countries.
Contact Us:
Future Market Insights Inc.
Christiana Corporate, 200 Continental Drive,
Suite 401, Newark, Delaware – 19713, USA
T: +1-347-918-3531
For Sales Enquiries: sales@futuremarketinsights.com
Website: https://www.futuremarketinsights.com
LinkedIn| Twitter| Blogs | YouTube